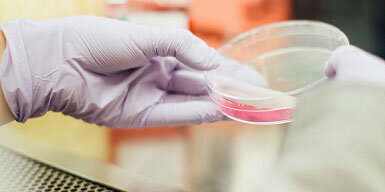
cell media facility

In keeping with the long history of the School of Chemical Sciences’ support of education and research at the University of Illinois, the SCS created the Center of Research and Educational Support (CORES) endowment. CORES honors the pioneering idea of world-renowned faculty while combating the loss of funding from federal and State sources. The CORES endowment ensures perpetual support for our researchers and facilities, providing the best equipment and greatest support staff to match the frontier research objectives of our faculty and students.
Shops & Services
Cell Media Facility

Electronics Services

Glass Shop






